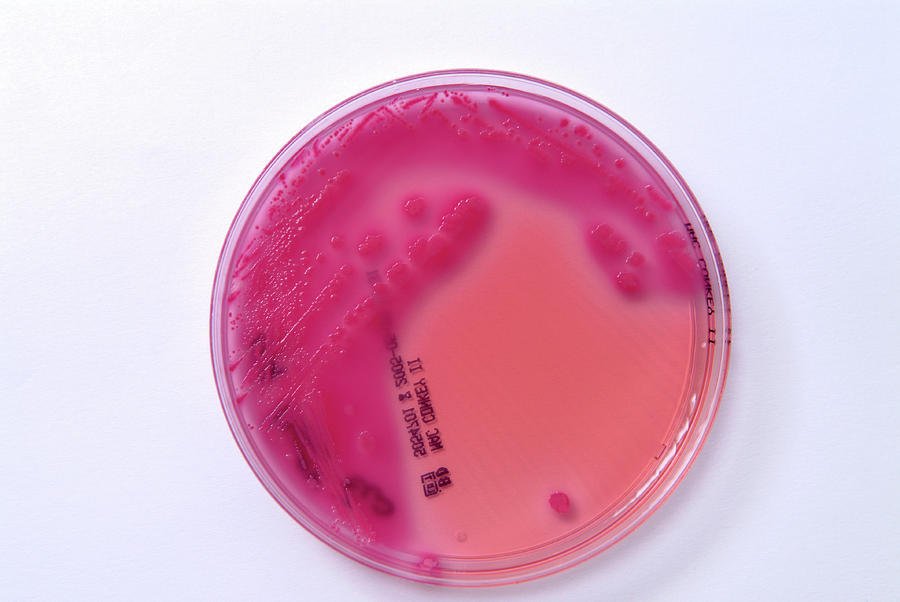
E. coli bacterial culture

Although E. coli is often implicated in the large-scale food poisoning outbreaks you see on the news, only a few strains of the bacteria actually cause disease. Escherichia coli, commonly known as E. coli, is naturally found in human and animal intestines to aid digestion and protect from harmful microbes. However, certain strains of E. coli, such as O157:H7, are pathogenic and produce toxins that irritate the intestines, provoking the classic symptoms of “food poisoning.” The most common of these pathotypes is termed Shiga toxin-producing E. coli (STEC), which includes E. coli O157:H7.1
Additionally, while most strains of E. coli are diarrheagenic, strains of uropathogenic E. coli (UPEC) cause urinary tract infections instead. 2
Causes of E. coli infection
If E. coli is only found in human and animal intestines, then how does it spread? Well, fecal contamination is more common than you might expect.
Eating contaminated food
Since E. coli is most commonly spread through foodborne pathways, eating contaminated produce or undercooked meat are the most likely culprits for infection. For fresh fruits and vegetables, runoff water from livestock farms can contaminate agricultural fields with animal fecal matter. 3 For meat and other animal products, fecal particles may be present on udders, hides, or processing equipment, making E. coli contamination likely if not cooked thoroughly. 4

Swimming in contaminated water
While eating contaminated food is the most common route of transmission, it is not the only way you can get sick. Pathogenic E. coli can also taint lakes and swimming pools, so accidentally swallowing or exposing open wounds to contaminated water can cause illness.5
Direct exposure to animals
Additionally, E. coli infection can occur with direct exposure to animals or their environments, such as petting zoos. Although E. coli cannot spread through skin contact, if someone touches their eyes, nose, or mouth after petting an infected animal, they may fall ill.6
Causes of UPEC infection
A UPEC infection occurs when E. coli enters the urinary tract, usually through fecal matter. This can occur during sex and from wiping “back to front” after using the washroom, as these can cause E. coli to travel from the anus to the urethra.7 Once the bacteria is in the urethra, it can reach the bladder—the most common location of urinary tract infections.8
Risk factors
Anyone can contract a STEC infection. In fact, they are quite common, with 265,000 cases estimated in the US each year.1 However, individuals with weakened immune systems are at greater risk of developing severe symptoms. This may include young children, the elderly, and those with immunodeficiency disorders.9
UPEC infections are also very common; 80-90% of all UTIs are caused by E. coli10 and about 2 in 5 women will experience a UTI in their lifetime11 . Women are far more likely to develop a urinary tract infection, as the anus and urethra are much closer together. Additionally, since the female urethra is shorter than the male’s, the bacteria has to travel a shorter distance to reach the bladder, making infection more likely.7

Symptoms
Symptoms of a STEC infection
Symptoms usually begin 3-4 days after exposure and resolve within a week. While most infections are mild, some can be life-threatening12
- Stomach pains and cramps
- Watery, often bloody diarrhea
- Loss of appetite or nausea
- Vomiting
- Fatigue
- Low fever (less than 101˚F/38.5˚C)13
Complications of STEC infections
Hemolytic uremic syndrome
Hemolytic uremic syndrome (HUS) is a rare condition that affects the kidneys, developing in up to 10% of individuals with an E. coli O157:H7 infection, most commonly children under the age of 5.14 During a STEC infection, the toxins produced by the bacteria may enter the bloodstream and destroy red blood cells. The damaged red blood cells then clog the glomeruli—the small blood vessels within the kidneys where blood is filtered—causing sudden kidney failure.15
HUS usually develops 1-2 weeks after the symptoms of E. coli first appear. Symptoms may include decreased urination, extreme fatigue, bruising, and paleness, particularly in the cheeks and inside the lower eyelids.16
Thrombotic thrombocytopenic purpura
Thrombotic thrombocytopenic purpura (TTP) is another blood condition that may arise as a complication of a STEC infection.17 It causes blood clots to form in small blood vessels throughout the body, restricting blood flow to organs such as the brain, kidneys, and heart and destroying red blood cells. Consequently, symptoms may include neurological problems (e.g. personality changes, headaches, confusion, slurred speech), decreased urination, extreme fatigue, paleness, and small red, purple, or brown spots on the skin.18
Symptoms of a UTI
- Frequent, strong urge to urinate
- Burning sensation during urination
- Cloudy, strong-smelling urine
- Bloody urine
- Pressure or cramping in the lower abdomen and pelvis7
Diagnosis
STEC infections are confirmed through laboratory testing of stool samples. Most labs can test for E. coli O157; however, non-O157 STEC strains can be identified by testing for the presence of Shiga toxins. Determining the specific strain of E. coli is essential for public health, as it helps identify outbreaks and monitor for emergent variants.1
Similarly, UTIs are confirmed through laboratory urine testing. Diagnosis is important, as identifying the type of bacteria may determine which antibiotic should be prescribed.19
Treatment
Treatment for STEC infections
Although there is no medical treatment for STEC infections, most go away on their own. Antibiotics are not typically administered for STEC infections as they may increase the risk of hemolytic uremic syndrome. Instead, simply drinking plenty of fluids is recommended to fight the dehydration that may be caused by diarrhea.1
Treatment for UPEC infections
Conversely, the gold standard treatment for a UTI is a short course of antibiotics. Pain is usually relieved soon after starting the antibiotics; however, it is crucial to finish the entire course to avoid recurrent infections.17
Prevention
Preventing STEC infections
- Practice proper hygiene
- Wash your hands after using the washroom and changing diapers
- Wash your hands before and after preparing or eating food
- Wash your hands after contact with animals and their environments
- Prepare foods safely
- Cook meats thoroughly, using a food thermometer to ensure the meat has reached an internal temperature of at least 70˚C
- Wash counters, cutting boards, and utensils after contact with raw meat
- Wash raw fruits and vegetables under running water
- Avoid raw or unpasteurized milk and dairy products
- Don’t swallow water when swimming20
Preventing UTIs
- Wipe “front to back” after using the washroom to prevent bacteria from the anal region from spreading to the vagina and urethra
- Pee as soon as possible after sex7
About Kraken Sense
Kraken Sense develops all-in-one pathogen detection solutions to accelerate time to results by replacing lab testing with a single field-deployable device. Our proprietary device, the KRAKEN, has the ability to detect bacteria and viruses down to 1 copy/mL. It has already been applied for epidemiology detection in wastewater and microbial contamination testing in food processing, among many other applications. Our team of highly-skilled Microbiologists and Engineers tailor the system to fit individual project needs. To stay updated with our latest articles and product launches, follow us on LinkedIn, Twitter, and Instagram, or sign up for our email newsletter. Discover the potential of continuous, autonomous pathogen testing by speaking to our team.
Sources
- https://www.cdc.gov/ecoli/general/index.html
- https://www.mdpi.com/2076-2607/10/3/645
- https://www.nrcs.usda.gov/Internet/FSE_DOCUMENTS/stelprdb1044367.pdf
- https://www.beefresearch.ca/topics/e-coli/
- https://www.cdc.gov/healthywater/swimming/swimmers/rwi.html
- https://www.webmd.com/baby/features/kids-petting-zoos
- https://www.nhs.uk/conditions/urinary-tract-infections-utis/
- https://www.mayoclinic.org/diseases-conditions/urinary-tract-infection/symptoms-causes/syc-20353447
- https://www.mayoclinic.org/diseases-conditions/e-coli/symptoms-causes/syc-20372058
- https://www.kidney.org/sites/default/files/uti.pdf
- https://www.urologyhealth.org/healthy-living/urologyhealth-extra/magazine-archives/summer-2016/understanding-utis-across-the-lifespan
- https://www.cdc.gov/ecoli/ecoli-symptoms.html
- https://my.clevelandclinic.org/health/diseases/16638-e-coli-infection
- https://www.ncbi.nlm.nih.gov/books/NBK507845/
- https://www.niddk.nih.gov/health-information/kidney-disease/children/hemolytic-uremic-syndrome
- https://www.mayoclinic.org/diseases-conditions/hemolytic-uremic-syndrome/symptoms-causes/syc-20352399
- https://www.ncbi.nlm.nih.gov/books/NBK430721/
- https://www.nhlbi.nih.gov/health/thrombotic-thrombocytopenic-purpura
- https://www.mayoclinic.org/diseases-conditions/urinary-tract-infection/diagnosis-treatment/drc-20353453
- https://www.cdc.gov/ecoli/ecoli-prevention.html


Leave a comment